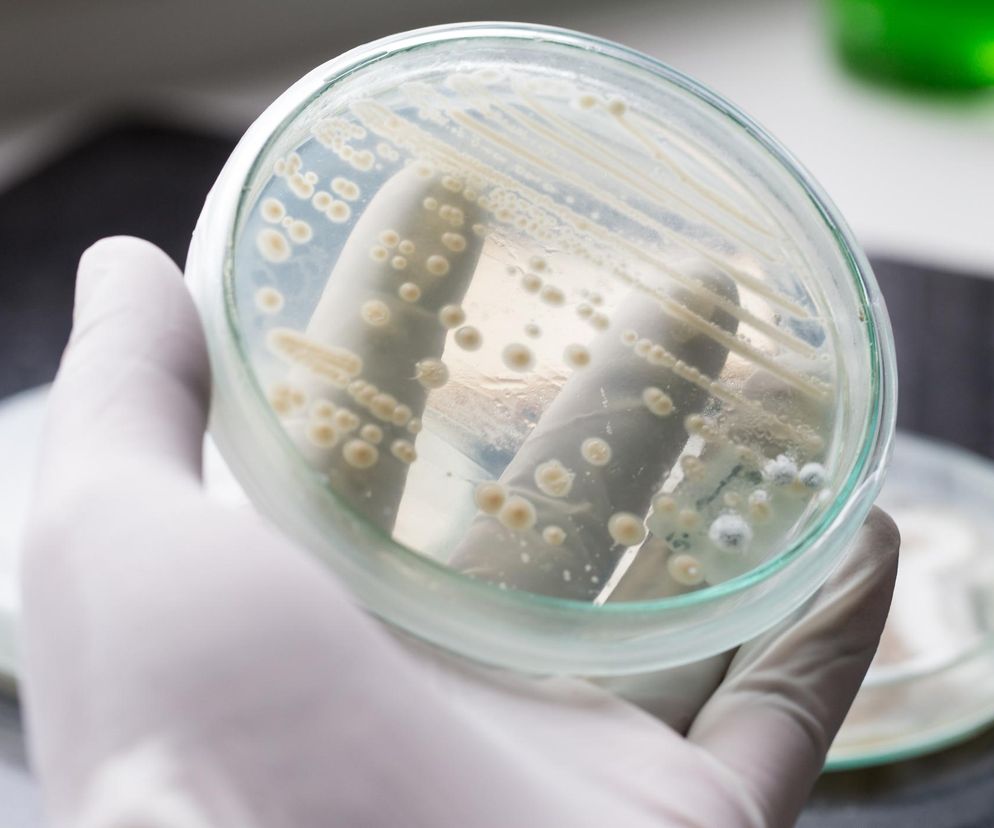

Infekcje intymne kobiet to jeden z najczęstszych powodów wizyt u ginekologa. Dobrze, bo samodzielne leczenie bez konsultacji ze specjalistą grozi nawrotem problemów. Dotyczy to zarówno infekcji bakteryjnych, grzybiczych (kandydoz), jak i mieszanych.
Wiele kobiet zwraca się po pomoc lekarską dopiero wtedy, gdy grzybica już nawraca. To kiepska strategia. Grzybica pochwy choć często bagatelizowana, nieleczona lub źle leczona, może prowadzić do poważnych powikłań, w tym problemów z płodnością.
Zrozumienie przyczyn i poznanie objawów oraz metod leczenia jest kluczowe dla skutecznej walki z nawracającą grzybicą pochwy, co staje się szczególnie ważne w okresie letnim, kiedy jesteśmy bardziej narażone na infekcje intymne.
Spis treści
Czym jest grzybica pochwy?
Grzybica pochwy, zwana również kandydozą, to infekcja wywołana przez grzyby z rodzaju Candida, najczęściej Candida albicans, Candida tropicalis i Candida glabrata.
Drożdżaki te naturalnie bytują w jamie ustnej i narządach płciowych wielu zdrowych kobiet, jednak do infekcji dochodzi, gdy następuje zaburzenie równowagi między ilością grzybów a "dobrymi" bakteriami. Wówczas grzyby namnażają się bez kontroli, zagrażając naszemu zdrowiu.
Przyczyny grzybicy pochwy
Grzybica pochwy jest chorobą przenoszoną drogą płciową, ale jest też wiele innych przyczyn jej rozwoju.
Do zaburzenia równowagi mikrobioty pochwy i rozwoju grzybicy przyczyniają się różne czynniki:
- antybiotykoterapia: antybiotyki niszczą zarówno bakterie chorobotwórcze, jak i prawidłową florę bakteryjną, co stwarza idealne warunki dla rozwoju grzybów
- antykoncepcja hormonalna: sama antykoncepcja nie powoduje grzybicy, ale niektóre środki antykoncepcyjne mogą wpływać na równowagę hormonalną i sprzyjać infekcjom, dlatego ich dobór pozostawiamy lekarzowi. Bywa, że wskazane jest stosowanie probiotyków ginekologicznych przy antykoncepcji hormonalnej
- cukrzyca i anemia: choroby te osłabiają układ odpornościowy i zwiększają podatność na różne infekcje
- osłabienie układu odpornościowego, także spowodowane przewlekłym stresem
- dieta bogata w cukier: cukier stwarza idealne środowisko dla rozwoju grzybów
- uszkodzenia okolic pochwy: nawet drobne otarcia ułatwiają grzybom wnikanie i kolonizację w waginie.
Sprawdź: od nastolatki do seniorki - ważne badania ginekologiczne
Wakacje, higiena i nawracająca grzybica pochwy
Nie można zapominać, że latem kobiety są szczególnie narażone na różne infekcje intymne ze względu na korzystanie z publicznych basenów, jacuzzi, sauny etc. Tak naprawdę wystarczy usiąść bez ręcznika na leżakach plażowych, by narobić sobie problemów.
Wilgotne środowisko, długotrwałe przebywanie w mokrym kostiumie kąpielowym oraz kontakt z innymi patogenami sprzyjają rozwojowi grzybicy.
Latem mamy też większą skłonność, by "wziąć cokolwiek", co powstrzyma nieprzyjemne objawy. Często ustępują, a potem nieraz szybko wracają.
Nieprawidłowa higiena intymna
Zarówno niedostateczna, jak i nadmierna higiena intymna mogą zaburzać naturalną florę bakteryjną pochwy. Irygacje pochwy wypłukują dobre bakterie, a niedostateczne podcieranie się (od odbytu w kierunku sromu) przenosi bakterie z jelita grubego do dróg rodnych. Zmieniona flora bakteryjna otwiera wrota kolejnym agresorom, w tym grzybom.

Typowe objawy grzybicy pochwy
Kiedy podejrzewać, że masz kandydozę? Zwykle towarzyszą jej charakterystyczne objawy:
- gęste, białawe lub żółtawe, twarogowate upławy o charakterystycznym zapachu "grzybów"
- świąd okolic pochwy
- zaczerwienienie i obrzęk okolic intymnych
- pieczenie podczas oddawania moczu
- ból podczas stosunku.
Ważne: Jeśli objawom towarzyszy gorączka, stany podgorączkowe lub ból brzucha, należy niezwłocznie skonsultować się z lekarzem. Przy pieczeniu podczas oddawania moczu także - to może być infekcja pęcherza.
Powikłania nieleczonej grzybicy pochwy
Nieleczona lub nieprawidłowo leczona grzybica pochwy może przejść w stan utajony i zaatakować szyjkę macicy, cewkę moczową oraz pęcherz moczowy.
Grozi też zapaleniem jajowodów i powstawaniem zrostów, które utrudniają zajście w ciążę.
Grzybica pochwy zwiększa ryzyko poronienia, przedwczesnego porodu lub zakażenia noworodka u kobiet w ciąży.
Wśród ciężarnych zdarza się często ze względu na zmiany hormonalne, zmiany pH i zaburzenia tolerancji glukozy.
Leczenie grzybicy pochwy
Grzybicę pochwy leczy się preparatami przeciwgrzybiczymi, dobranymi przez lekarza, np. nystatyną, natamycyną i klotrimazolem w postaci globulek dopochwowych.
W przypadku nawracających infekcji wskazane bywa leczenie ogólnoustrojowe (doustne).
Dlaczego infekcje grzybicze nawracają?
Nawrotom infekcji grzybiczych sprzyja nieusunięcie ich przyczyn oraz nieprawidłowości podczas leczenia.
Należy:
- nie przerywać kuracji, nawet jeśli nastąpi poprawa
- zachować abstynencję seksualną podczas leczenia
- zastosować leczenie u partnera, by nie doszło do ponownego zarażenia
- stosować probiotyki ginekologiczne, które przywracają prawidłową florę bakteryjną pochwy.
Niedoleczona infekcja, źle dobrany preparat, utrzymujące się zaburzenia mikrobioty pochwy, infekcja mieszana (bakteryjno-grzybicza) - to wszystko sprzyja nawrotom.
W przypadku nawracającej infekcji należy wykonać dodatkowe badania (biocenozę i posiew z antybiogramem) i wdrożyć na stałe probiotyki ginekologiczne.
Preparaty na grzybicę pochwy bez recepty - to ma sens?
Dostępne są preparaty na grzybicę pochwy bez recepty, jednak w przypadku infekcji intymnej zawsze należy skonsultować się z lekarzem. Leki bez recepty mogą złagodzić objawy, ale często nie wyleczą infekcji.